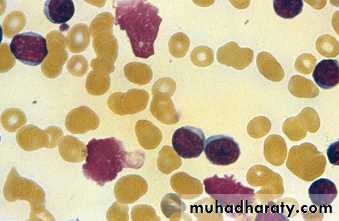

Chronic Lymphocytic Leukaemia
Dr. Ali Abdulrahman YounisChronic lymphocytic leukaemia(CLL)
The most common variety of leukaemia (30% ).The male to female ratio is 2 : 1
The median age at presentation is 65–70 years.
B lymphocytes fail to respond to antigens by transformation and antibody formation.
An everincreasing mass of immuno-incompetent cells accumulates, to the detriment of immune function and normal bone marrow haematopoiesis.
Clinical features
The onset is usually insidious.The diagnosis is made incidentally on a routine FBC in 70% of patients.
Presenting problems may be anaemia, infections, painless lymphadenopathy, and systemic symptoms such as night sweats or weight loss (late presentation).
Investigations
The diagnosis is based on the peripheral blood findings of a mature lymphocytosis (>5 ×109/L) with characteristic morphology and cell surface markers.Immunophenotyping reveals the lymphocytes to be monoclonal B cells expressing the B cell antigens CD19 and CD23, with either kappa or lambda immunoglobulin light chains and, characteristically, an aberrant T cell antigen, CD5.
Investigations
Other useful investigations in CLL include a reticulo cyte count and a direct Coombs test, as autoimmune haemolytic anaemia may occur .Serum immunoglobulin levels should be estimated to establish the degree of immunosuppression (common
and progressive).
Bone marrow examination by aspirate and trephine is not essential for the diagnosis of CLL, but may be helpful in difficult cases, for prognosis and to monitor response to therapy.
Prognostic factors
Stage of disease (the main prognostic factor)Malignant cell characteristics, such as CD38 expression, abnormalities of chromosome 11 or 17, and absence of mutations of IgVH genes.
Staging of chronic lymphocytic leukemia
Management
No specific treatment is required for most clinical stage A patients, unless progression occurs.Life expectancy is usually normal in older patients.
The patient should be offered clear information about CLL, and be reassured about the indolent nature of the disease .
Treatment indications
Evidence of bone marrow failure.
Massive or progressive lymphadenopathy or splenomegaly.Systemic symptoms such as weight loss or night sweats.
Rapidly increasing lymphocyte count or autoimmune haemolytic anaemia or thrombocytopenia.
Therapeutic agents
Initial therapy for those requiring treatment (stages B and C) may consist of oral chemotherapy with the alkylating agent chlorambucil (reduce the abnormal lymphocyte mass and produce symptomatic improvement).The purine analogue fludarabine, in combination with the alkylating agent cyclophosphamide and the antiCD20 monoclonal antibody rituximab, has increased remission rates and diseasefree survival (increased risks of infection and secondary malignancies).
Bone marrow failure or autoimmune cytopenias may respond to corticosteroids.
Other therapeutic measures
Supportive care is increasingly required in progressive disease, e.g. transfusions for symptomatic anaemia or thrombocytopenia, prompt treatment of infections and, for some patients with hypogammaglobulinaemia, immunoglobulin replacement.Radiotherapy may be used for lymphadenopathy (discomfort or local obstruction), and for symptomatic splenomegaly.
Splenectomy may be required to improve low blood counts due to autoimmune destruction or to hypersplenism, and can relieve massive splenomegaly.
Prognosis
The majority of clinical stage A patients have a normal life expectancy but patients with advanced CLL are more likely to die from their disease or infectious complications.Survival is influenced by prognostic features of the leukaemia and whether patients can tolerate intensive treatment.
In those treated with chemotherapy and rituximab, 90% are alive 4 years later.
Rarely, CLL transforms to an aggressive highgrade lymphoma, called Richter’s transformation.
THANKS